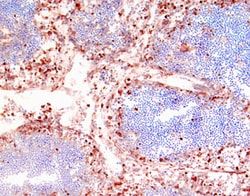
Img

Human CD27/TNFRSF7 Biotinylated Antibody, R&D Systems™
Manufacturer: R&D Systems
Select a Size
| Pack Size | SKU | Availability | Price |
|---|---|---|---|
| Each of 1 | BAF382-Each-of-1 | In Stock | ₹ 54,156.50 |
BAF382 - Each of 1
In Stock
Quantity
1
Base Price: ₹ 54,156.50
GST (18%): ₹ 9,748.17
Total Price: ₹ 63,904.67
Antigen
CD27/TNFRSF7
Classification
Polyclonal
Conjugate
Biotin
Gene Accession No.
P26842
Gene Symbols
CD27
Immunogen
S. frugiperdainsect ovarian cell lineSf21-derived recombinant human CD27 Thr21-Ile192 Accession # P26842
Quantity
50 μg
Primary or Secondary
Primary
Test Specificity
Detects human CD27 in Western blots. In Western blots, less than 2% cross-reactivity with recombinant human (rh) sTNF RI and rhsTNF RII (under reducing conditions) is observed.
Target Species
Human
Isotype
IgG
Applications
Western Blot, Flow Cytometry, Immunohistochemistry
Concentration
LYOPH
Dilution
Western Blot 0.1 ug/mL, Flow Cytometry 2.5 ug/10^6 cells, Immunohistochemistry 3-15 ug/mL
Gene Alias
CD27, CD27 antigen, CD27 molecule, MGC20393, S152CD27L receptor, T cell activation antigen CD27, T cell activation antigen S152, T14, TNFRSF7, TNFRSF7T-cell activation antigen CD27, Tp55, Tumor necrosis factor receptor superfamily member 7, tumor necrosis factor receptor superfamily, member 7
Host Species
Goat
Purification Method
Affinity Purified
Regulatory Status
RUO
Gene ID (Entrez)
939
Reconstitution
Reconstitute at 0.2 mg/mL in sterile PBS.
Content And Storage
Use a manual defrost freezer and avoid repeated freeze-thaw cycles.12 months from date of receipt, -20 to -70 degreesC as supplied. 1 month, 2 to 8 degreesC under sterile conditions after reconstitution. 6 months, -20 to -70 degreesC under sterile conditions after reconstitution.
Description
- CD27/TNFRSF7 Polyclonal specifically detects CD27/TNFRSF7 in Human samples
- It is validated for Western Blot, Flow Cytometry, Immunohistochemistry.